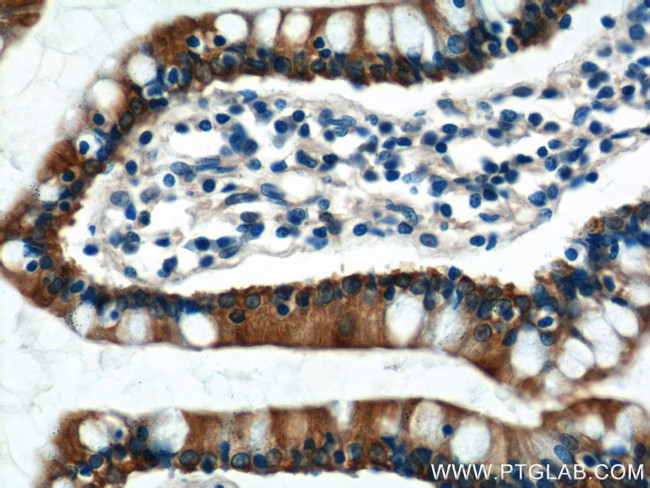
KAZALD1 Antibody in Immunohistochemistry (Paraffin) (IHC (P))
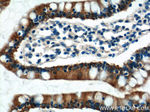
KAZALD1 Antibody in Immunohistochemistry (Paraffin) (IHC (P))

Search
Proteintech
KAZALD1 Polyclonal Antibody
{{$productOrderCtrl.translations['antibody.pdp.commerceCard.promotion.promotions']}}
{{$productOrderCtrl.translations['antibody.pdp.commerceCard.promotion.viewpromo']}}
{{$productOrderCtrl.translations['antibody.pdp.commerceCard.promotion.promocode']}}: {{promo.promoCode}} {{promo.promoTitle}} {{promo.promoDescription}}. {{$productOrderCtrl.translations['antibody.pdp.commerceCard.promotion.learnmore']}}
产品信息
20815-1-AP
种属反应
宿主/亚型
分类
类型
抗原
偶联物
形式
浓度
规格
纯化类型
保存液
内含物
保存条件
运输条件
产品详细信息
Immunogen sequence: RPSPGPDYL RRGWMRLLAE GEGCAPCRPE ECAAPRGCLA GRVRDACGCC WECANLEGQL CDLDPSAHFY GHCGEQLECR LDTGGDLSRG EVPEPLCACR SQSPLCGSDG HTYSQICRLQ EAARARPDAN LTVAHPGPCE SGPQIVSHPY DTWNVTGQDV IFGCEVFAYP MASIEWRKDG LDIQLPGDDP HISVQFRGGP QRFEVTGWLQ IQAVRPSDEG TYRCLGRNAL GQVEAPASLT VLTPDQLNST GIPQLRSLNL VPEEEAESEE NDDYY (31-304 aa encoded by B C007758)
靶标信息
This gene encodes a secreted member of the insulin growth factor-binding protein (IGFBP) superfamily. It contains an N-terminal insulin growth factor-binding domain, a central Kazal-type serine protease inhibitor and follistatin-like domain, and a C-terminal immunoglobulin-like domain. Studies of the mouse ortholog suggest that this gene product may have a function in bone development and bone regeneration.
仅用于科研。不用于诊断过程。未经明确授权不得转售。
篇参考文献 (0)
生物信息学
蛋白别名: bone- and odontoblast-expressed gene 1; FLJ24094; IGFBP-related protein 10; Kazal-type serine protease inhibitor domain-containing protein 1; novel kazal-type serine protease inhibitor domain and immunoglobulin domain containing protein; unnamed protein product
基因别名: BONO1; FKSG28; FKSG40; IGFBP-rP10; KAZALD1; UNQ2945/PRO21184
UniProt ID: (Human) Q96I82
Entrez Gene ID: (Human) 81621